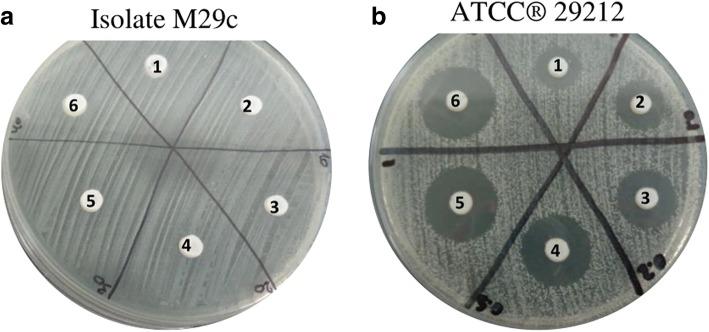

两种用于犬牙菌斑生物膜的乳酸链球菌素局部应用递送系统的潜力。
Potential of two delivery systems for nisin topical application to dental plaque biofilms in dogs.
作者信息
Cunha Eva, Trovão Tiago, Pinheiro Ana, Nunes Telmo, Santos Raquel, Moreira da Silva Jorge, São Braz Berta, Tavares Luís, Veiga Ana Salomé, Oliveira Manuela
机构信息
CIISA - Centro de Investigação Interdisciplinar em Sanidade Animal, Faculdade de Medicina Veterinária, Universidade de Lisboa, Avenida da Universidade Técnica, 1300-477, Lisboa, Portugal.
Instituto de Medicina Molecular, Faculdade de Medicina, Universidade de Lisboa, Avenida Professor Egas Moniz, 1649-028, Lisboa, Portugal.
出版信息
BMC Vet Res. 2018 Nov 29;14(1):375. doi: 10.1186/s12917-018-1692-9.
BACKGROUND
Periodontal disease (PD) is caused by the development of a microbial biofilm (dental plaque) in the periodontium, affecting approximately 80% of dogs. Several bacterial species present in the canine oral cavity can be implicated in the development of this disease, including Enterococcus spp. To decrease antibiotic administration, a possible control strategy for dog's enterococcal PD may involve the use of the antimicrobial peptide (AMP) nisin. Nisin's inhibitory activity was evaluated against a collection of previously characterized enterococci obtained from the oral cavity of dogs with PD (n = 20), as well as the potential of a guar-gum gel and a veterinary toothpaste as topical delivery systems for this AMP. The Minimum Inhibitory (MIC) and Bactericidal Concentrations (MBC) and the Minimum Biofilm Eradication (MBEC) and Inhibitory Concentrations (MBIC) were determined for nisin and for the supplemented guar-gum gel. For the supplemented veterinary toothpaste an agar-well diffusion assay was used to evaluate its inhibitory potential.
RESULTS
Nisin was effective against all isolates. Independently of being or not incorporated in the guar-gum gel, its inhibitory activity on biofilms was higher, with MBIC (12.46 ± 5.16 and 13.60 ± 4.31 μg/mL, respectively) and MBEC values (21.87 ± 11.33 and 42.34 ± 16.61 μg/mL) being lower than MIC (24.61 ± 4.64 and 14.90 ± 4.10 μg/mL) and MBC (63.09 ± 13.22 and 66.63 ± 19.55 μg/mL) values. The supplemented toothpaste was also effective, showing inhibitory activity against 95% of the isolates.
CONCLUSIONS
The inhibitory ability of nisin when incorporated in the two delivery systems was maintained or increased, demonstrating the potential of these supplemented vehicles to be applied to PD control in dogs.
背景
牙周病(PD)是由牙周组织中微生物生物膜(牙菌斑)的形成引起的,约80%的犬类受其影响。犬口腔中存在的几种细菌物种可能与该疾病的发生有关,包括肠球菌属。为了减少抗生素的使用,一种针对犬肠球菌性牙周病的可能控制策略可能涉及使用抗菌肽(AMP)乳酸链球菌素。评估了乳酸链球菌素对从患有牙周病的犬口腔中分离得到的一组先前已鉴定的肠球菌(n = 20)的抑制活性,以及瓜尔胶凝胶和兽用牙膏作为该抗菌肽局部递送系统的潜力。测定了乳酸链球菌素以及添加了乳酸链球菌素的瓜尔胶凝胶的最低抑菌浓度(MIC)、杀菌浓度(MBC)、最低生物膜清除浓度(MBEC)和抑制浓度(MBIC)。对于添加了乳酸链球菌素的兽用牙膏,采用琼脂孔扩散试验评估其抑制潜力。
结果
乳酸链球菌素对所有分离株均有效。无论是否掺入瓜尔胶凝胶中,其对生物膜的抑制活性都更高,MBIC值(分别为12.46±5.16和13.60±4.31μg/mL)和MBEC值(分别为21.87±11.33和42.34±16.61μg/mL)低于MIC值(分别为24.61±4.64和14.90±4.10μg/mL)和MBC值(分别为63.09±13.22和66.63±19.55μg/mL)。添加了乳酸链球菌素的牙膏也有效,对95%的分离株显示出抑制活性。
结论
乳酸链球菌素掺入两种递送系统时的抑制能力得以维持或增强,表明这些添加了乳酸链球菌素的载体在犬牙周病控制中的应用潜力。